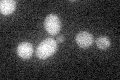
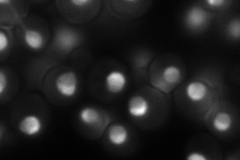
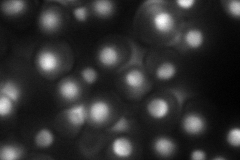
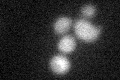

View description
Nucleolar protein involved in the assembly and export of the large ribosomal subunit; constituent of 66S pre-ribosomal particles; contains a sigma(70)-like motif, which is thought to bind RNA
Localization:
Intensity:
Fold change:
Significance:
-
C’ GFP library in SD
below threshold16.75 -
N' NOP1pr-GFP in SD
nucleolus135.068 -
N' TEF2pr-mCherry in SD
punctate,nucleus103.233 -
N' NATIVEpr-GFP in SD

nucleus,nucleolus83.088 -
N' TEF2pr-VC and Cyto-VN in SD

nucleus,nucleolus43.4459 -
C’ GFP library in SD+DTT
cytosol17.851.06No -
C’ GFP library in SD+H2O2

cytosol16.410.97No -
C’ GFP library in Starvation Media

cytosol16.090.96No -
C’ GFP library on the background of Pup2-DaMP

below threshold -
C’ GFP library on the background of CCT mutant

below threshold20.60981.22944No
